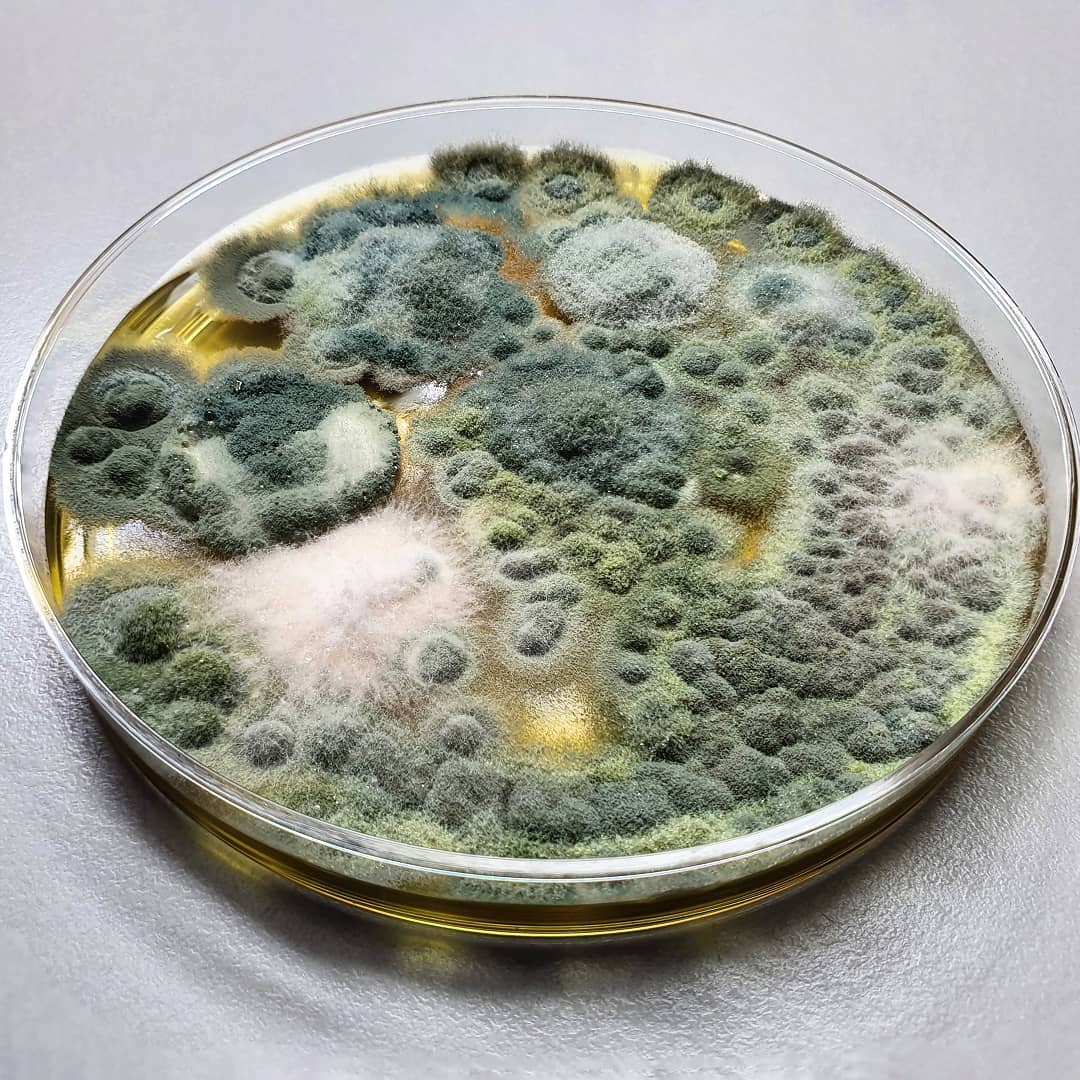

¿A QUÉ REINO DE LA CLASIFICACIÓN DE LOS SERES VIVOS PERTENECEN LOS HONGOS?
EUMYCOTA
¿QUE MATERIAL BIOLÓGICO ES UTIL PARA DIAGNÓSTICAR UNA TIÑA DE CUERPO?
ESCAMAS DE PIEL
¿A QUÉ AGENTE ETIOLÓGICO CORRESPONDE ESTA IMAGEN?
MALASSEZIA SP
 ¿A QUE TIPO DE TIÑA CORPORIS CORRESPONDE ESTE CUADRO CLÍNICO?
¿A QUE TIPO DE TIÑA CORPORIS CORRESPONDE ESTE CUADRO CLÍNICO?
TIÑA MICROSPORICA
¿CUÁL ES EL PRINCIPAL AGENTE ETIOLÓGICO DE LA TIÑA DE BARBA?
T.MENTAGROPHYTES
¿CUÁL ES EL COMPONENTE PRINCIPAL DE LA PARED CELULAR DE LOS HONGOS?
QUITINA
¿QUE MEDIO DE CULTIVO ES IDEAL PARA EL DESARROLLO DE HONGOS?
AGAR DEXTROSA SABORAUD
AGAR DEXTROSA SABORAUD
 ¿A QUÉ ESPECIE DE HONGOS FILAMENTOS PERTENECE ESTA COLONIA?
¿A QUÉ ESPECIE DE HONGOS FILAMENTOS PERTENECE ESTA COLONIA?
T. rubrum
¿CUAL ES EL AGENTE ETIOLÓGICO MÁS COMÚN DE ESTA PRESENTACIÓN CLÍNICA?
T. TONSURANS
SP?
LEVADURIFORME
SAPROTROFOS
¿CON QUE OTRO NOMBRE SE LES DENOMINA A ESTAS HIFAS?
HIFAS NO CENOCITICAS
 ¿A QUÉ TIPO DE PARASITACIÓN DE PELO PERTENECE ESTA IMAGEN?
¿A QUÉ TIPO DE PARASITACIÓN DE PELO PERTENECE ESTA IMAGEN?
ENDOTRIX O TRICOFITICO
 ¿CUAL ES EL PRINCIPAL AGENTE ETIOLOGICO DE ESTA PRESENTACIÓN CLÍNICA?
¿CUAL ES EL PRINCIPAL AGENTE ETIOLOGICO DE ESTA PRESENTACIÓN CLÍNICA?
T. RUBRUM
DMORFISMO
AGAR SABPURAUN+ ACITE DE OLIVA O AGAR DIXON MODIFICADO
 ¿A QUÉ DERMATOFITO CORRESPONDEN LAS SIGUIENTES IMAGENES?
¿A QUÉ DERMATOFITO CORRESPONDEN LAS SIGUIENTES IMAGENES?
MICROSPORUM CANIS
 ¿QUÉ GÉNERO DE DERMATOFITOS CAUSA ESTA PARASITACIÓN CON MAYOR FRECUENCIA?
¿QUÉ GÉNERO DE DERMATOFITOS CAUSA ESTA PARASITACIÓN CON MAYOR FRECUENCIA?
MICROSPORUM SPP
¿CUÁL ES LA TRIADA CARACTERISTICA DE LA TIÑA DE CABEZA?
PLACAS PSEUDOALOPECICAS, ESCAMAS Y PELOS CORTOS
¿CUÁL ES LA DEFINICIÓN DE MICOTOXICOSIS?
ALTERACIÓN PRODUCIDA POR LA INGESTION DE MICOTOXINAS
¿QUÉ PROCEDIMIENTO DEBE REALIZARSE EN MUESTRAS DE TEJIDO QUERATINIZADOS PARA EXPONER EL MICELIO SIN ARTEFACTOS?
ACLARAMIENTO CON KOH
 ¿ A QUÉ AGENTE ETIOLÓGICO CORRESPONDE ESTAS IMAGENES?
¿ A QUÉ AGENTE ETIOLÓGICO CORRESPONDE ESTAS IMAGENES?
 ¿A QUÉ AGENTE ETIOLÓGICO CORRESPONDE ESTAS IMAGENES?
¿A QUÉ AGENTE ETIOLÓGICO CORRESPONDE ESTAS IMAGENES?
E.FLOCOSUM
¿CUAL ES UN HONGO ZOOFILICO?
MICROSPORUM CANIS